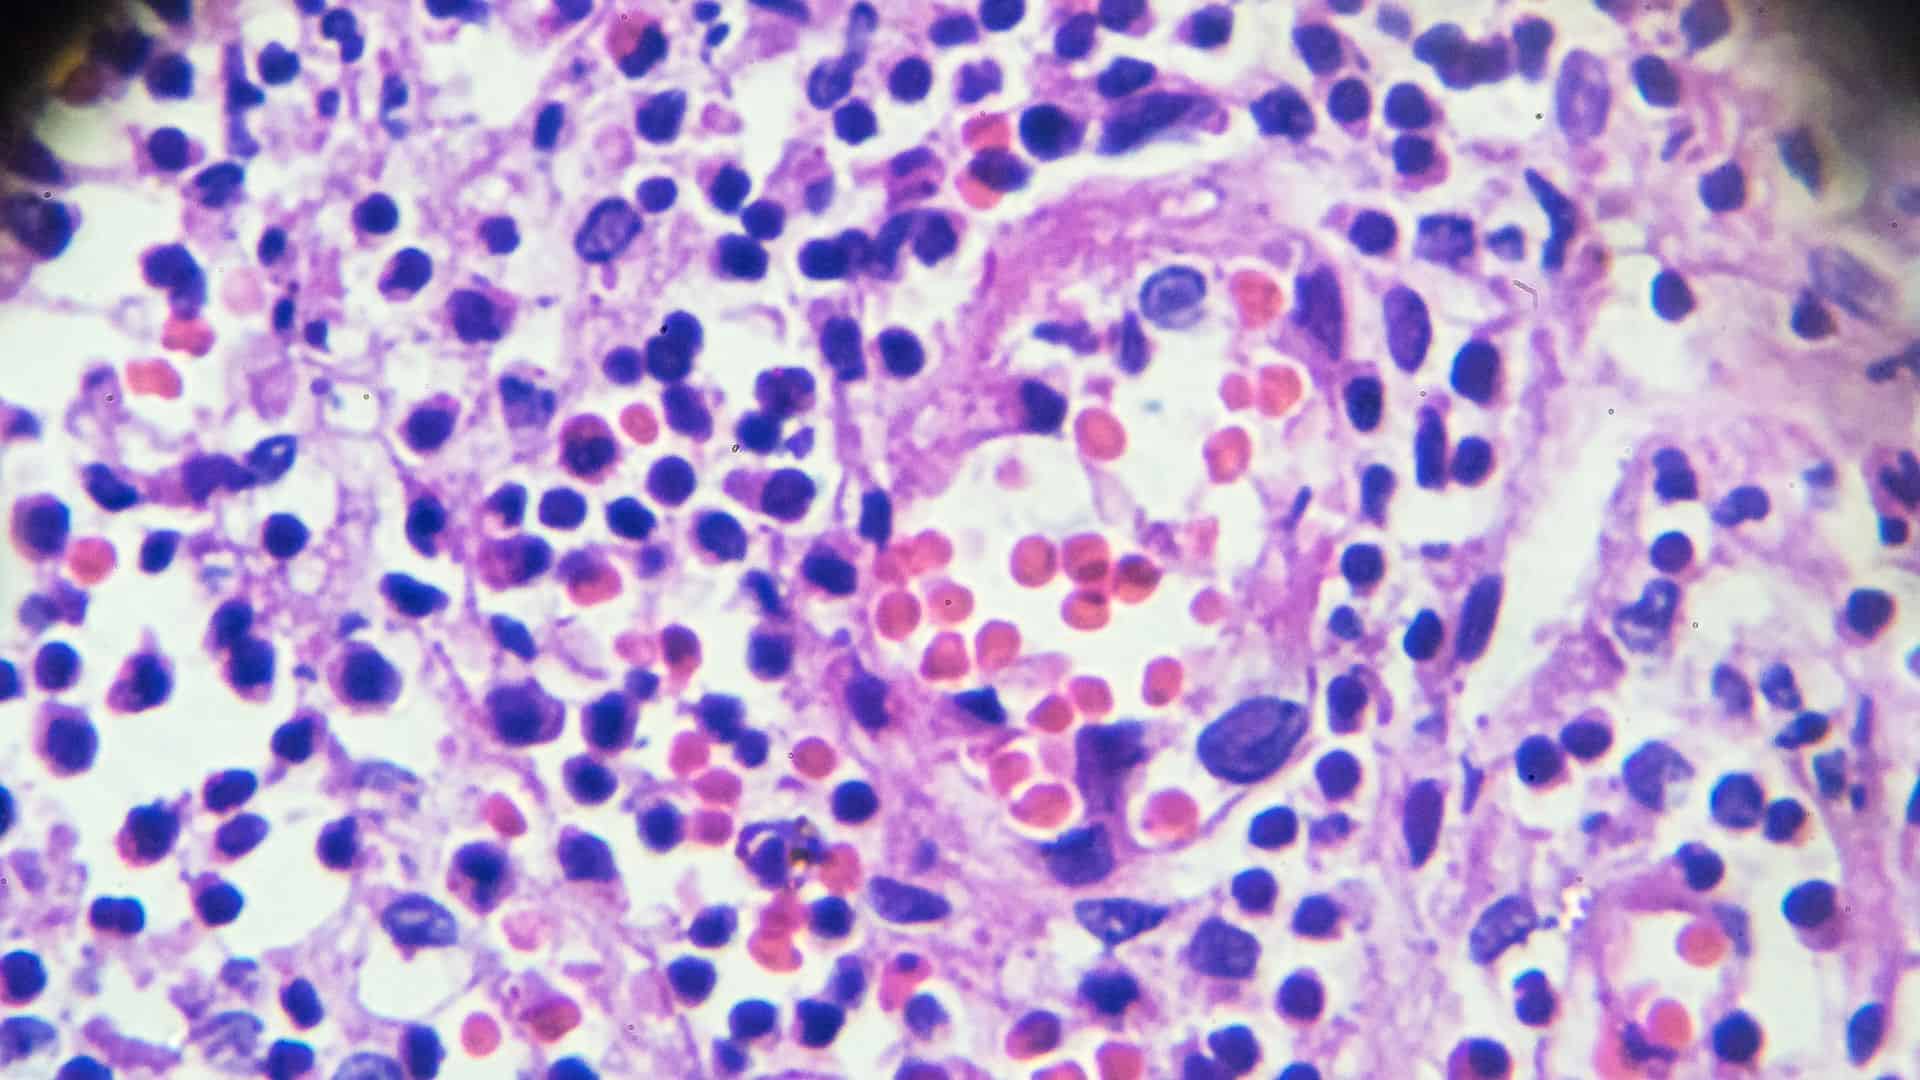

I was so confused. I received my pathology report indicating I had cancer, but after meeting with my doctor, I was left with more questions than answers. I connected with HONEST Pathology, the learning experience and advice was priceless. Knowledge is power! The platform allowed me to seamlessly connect with a pathologist on my schedule with zero technical issues.